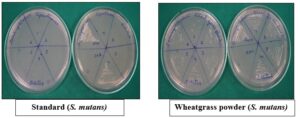

- Next story Review of Drimia indica in Terms of Geographical Distribution, Phytochemistry, Pharmacology and Toxicity
- Previous story Computational Design and ADME Profiling of Thienopyrimidine-Based Dual VEGFR/EGFR Inhibitors for Anticancer Drug Discovery







Certificate
vials
3203_app_sta-lite_liquid_polydextrose_pharmaceuticals
online-pharmacy-1
genetic-thermometer-telomere-shutterstock_121112536-617x416
Prescription Medication Spilling From an Open Medicine Bottle
Female Scientific Research Team With Clear Solution In Laborator
Statistics
| License: |  |
| Start Year: | 2010 |
| ISSN Registration: | NISCAIR |
| Country Base: | India |
| SJIF Impact Factor: | 8.332 |
| Open Access: | Yes |
| Peer Reviewed: | Yes |
| Issues Per Year: | 12 |
Indexing
Best Paper Award
Journal of Current Pharma Research (JCPR) will give best paper award every year in the form of money along with certificate to support research activity of scholar.
News & Updates
It’s our pleasure to inform you that, JCPR Issue has been Published.
Articles are Invited for Publication.
Please send your articles to [email protected]